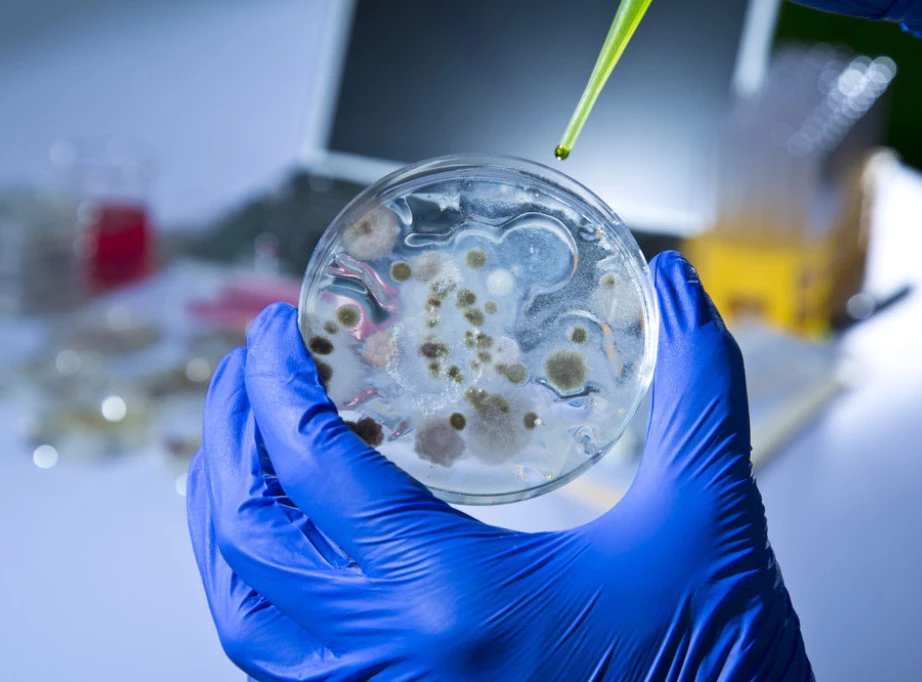
Više od 150 osoba na kruzeru koji je obilazio Karibe obolelo od norovirusa Foto: Shutterstock.com/CASTALDOstmudio.co/Ilustracija

NJUJORK – Više od 150 osoba na kruzeru Star princes, koji je obilazio Karibe, razbolelo se od norovirusa, saopštil su američki Centri za kontrolu i prevenciju bolesti (CDC), preneo je danas NBC njuz.
Od virusa su obolela 104 putnika, kao i 49 članova posade, saopštio je CDC.
Brod je bio na jednonedeljnom putovanju koje se završilo danas, a putnici i članovi posade su imali simptome kao što su dijareja i povraćanje, navodi se u saopštenju.
Izvor: Tanjug